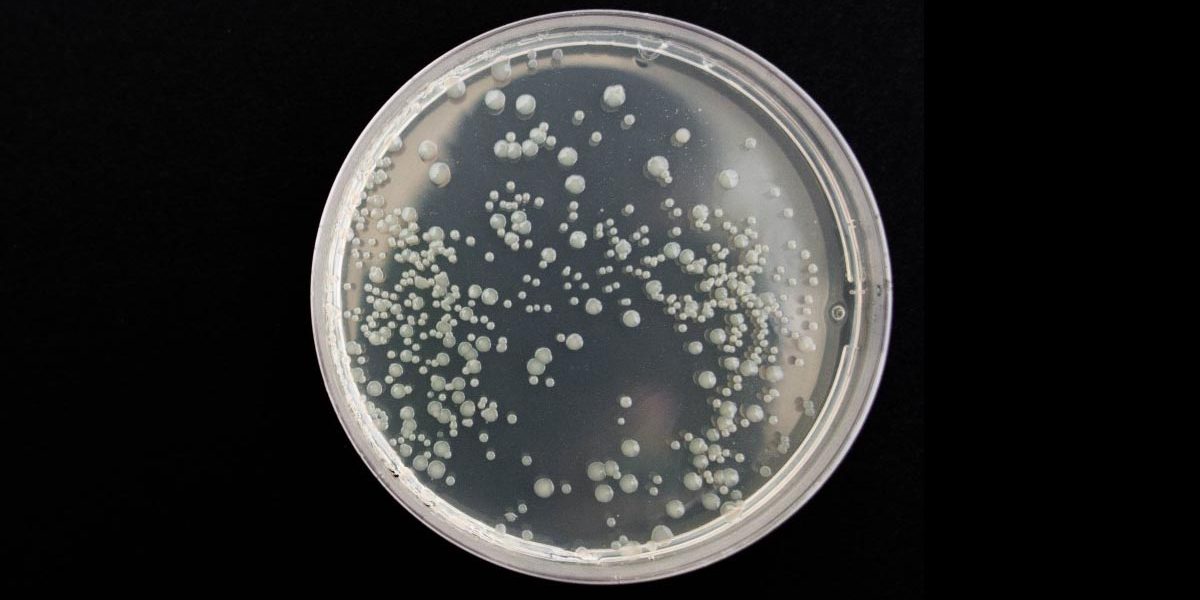
bronchitis Poultry Chicken Bronchitis

Bronchitis is an airborne coronavirus caught from proximity or contact with other infected animals which can be contracted by chickens of any age.
- At risk:
- Chickens of any age
- Symptoms:
- Sneezing
- Coughing
- Watery discharge from nose
- Slow down or stop in laying
- Cause:
- Airborne virus caught from proximity or contact with other infected animals
- Treatment:
- Tender loving care
- Higher mortality rate in chicks than mature chickens
- Bronchitis Prevention:
- There is a vaccine available – check with vet or state department of agriculture
- Avoid contact with other flocks
- Quarantine birds after shows before re-introducing into the larger flock
For detailed information on other common ailments, see related posts below.